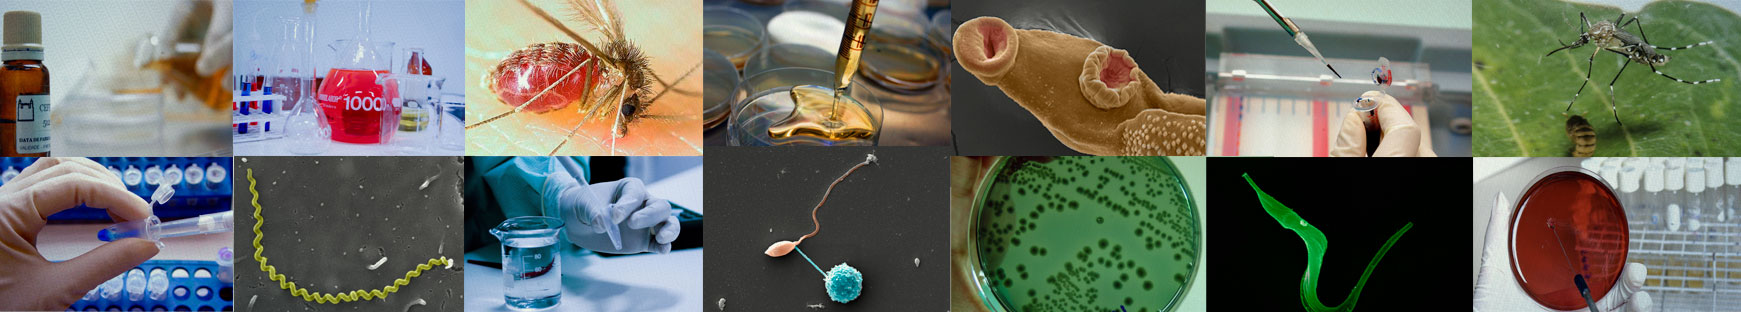

Vacina, Diagnóstico e Tratamento
Como instituição de pesquisa voltada para o aperfeiçoamento do Sistema Único de Saúde (SUS), a Fiocruz Bahia busca contribuir para o desenvolvimento de vacinas, métodos diagnósticos e no tratamento em todas as enfermidades onde atua. Trabalhamos em vacinas para as leishmanioses, na avaliação de vacinas contra o HPV e dengue, entre outras. A nossa atuação […]